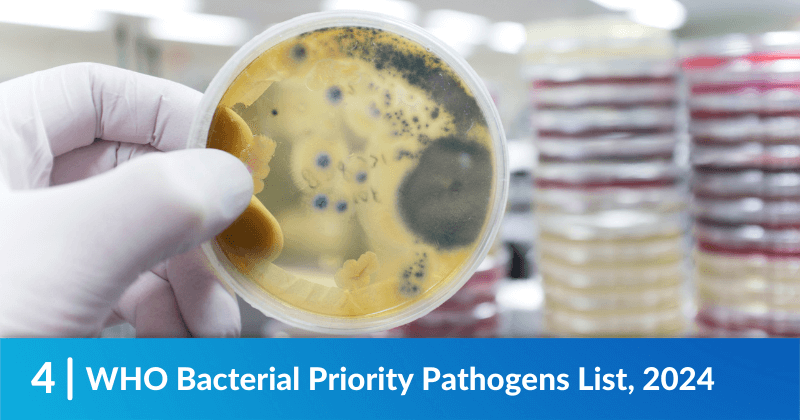
WHO Bacterial Priority Pathogens List, 2024

Five on Friday: Heat, H5N1, and More

Welcome back! It is another concerning week on the avian flu front, but we have two Weekly Wins at the end to lift your spirits! Join us in reading our picks for Five on Friday!
Robert sent in Climate Rights International’s new heat report exploring the consequences of extreme heat in the context of climate change and human rights. CRI Heat Report: 'I Can't Cool'.
Amy was quoted in a new piece from the Guardian discussing the risk faced by dairy workers as the avian flu has passed from cows to people. As Avian Flu Hops to Cows and at Least Two Humans, Migrant Farm Workers Are at Risk.
But there are more developments for Avian flu. Just yesterday, Michigan’s health department announced a third case among dairy farmers. Another Human Case of Bird Flu Detected in Michigan.
Weekly Win: WHO’s Bacterial Priority Pathogens List looks at anti-microbial resistance, naming tuberculosis as an important disease to follow as we look at drug resistance. Del sent this in, celebrating the inclusion of TB, a much overlooked and incredibly dangerous disease. WHO Bacterial Priority Pathogens List, 2024.
Weekly Win: Elizabeth celebrated a federal court decision with us – blocking section 10 of SB 1718 in Florida! The section threatened people with felonies for doing something as simple as driving an unauthorized immigrant to the doctor. Federal Court Temporarily Blocks Key Provision of Florida’s Anti-Immigrant SB 1718.
![]()
Have a safe and healthy weekend!
- Log in to post comments